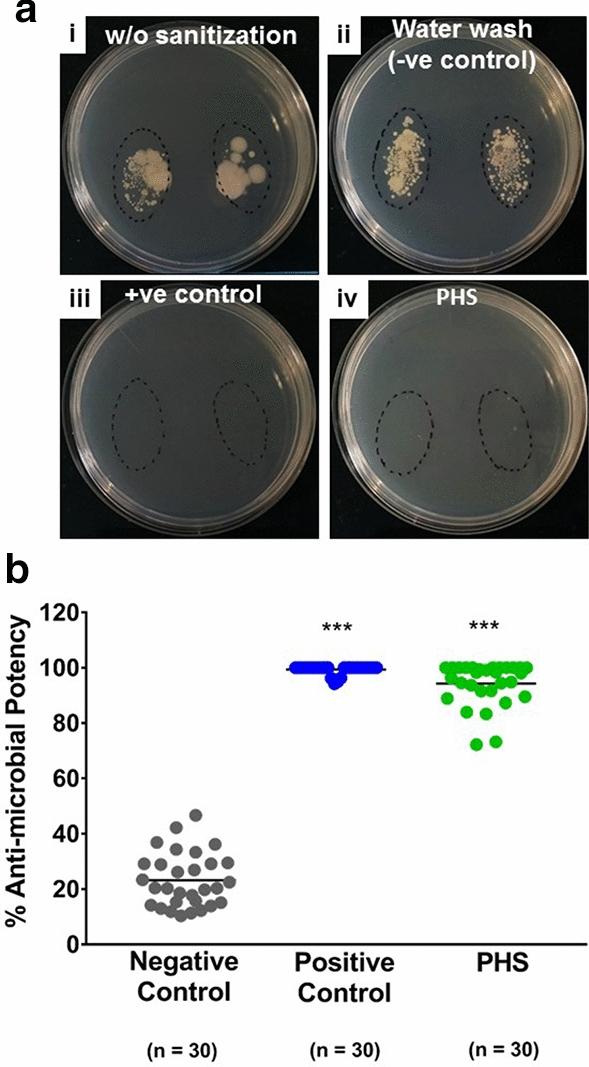
https://cdn.ncbi.nlm.nih.gov/pmc/blobs/d26d/7708568/482a6c579dad/13568_2020_1151_Fig1_HTML.jpg

GermiX:一款对皮肤友好的洗手液,对病原菌具有长效抗菌效果。
GermiX: A skin friendly hand sanitizer with prolonged effectivity against pathogenic bacteria.
作者信息
Balkrishna Acharya, Singh Kanchan, Singh Hoshiyar, Haldar Swati, Varshney Anurag
机构信息
Drug Discovery and Development Division, Patanjali Research Institute (Governed By Patanjali Research Foundation Trust), Roorkee-Haridwar Road, Haridwar, Uttarakhand, 249405, India.
Department of Allied and Applied Sciences, University of Patanjali, NH-58, Haridwar, Uttarakhand, 249405, India.
出版信息
AMB Express. 2020 Dec 1;10(1):210. doi: 10.1186/s13568-020-01151-y.
COVID-19 pandemic has almost made hand sanitization a ritual resulting in a steep increase in the frequency of hand sanitization and an unprecedented surge in demand for hand sanitizers. In fact, several governments had to ration hand sanitizers in the retail outlets and over the counter chemist shops. Additionally, Indian government has put a cap on the prices of hand sanitizers. Currently, large sections of global and Indian population are grappling under financial crises. Therefore, mandatory hand sanitization has made an unwelcoming, yet unavoidable addition to the already-hard-to-maintain-grocery-list. Here, we have compared the anti-microbial efficacy of Patanjali Hand Sanitizer (PHS), developed and marketed by Patanjali Ayurved Ltd. (an India-based food and herbal medicine company) with one of the topmost hand sanitizers currently used under clinical set-ups. PHS has anti-microbial efficacy comparable to that of the standard hand sanitizer. Besides, disc diffusion and time-dependent thumb print assays showed that PHS has longer retentivity on the applied surfaces, suggesting lesser consumption of the sanitizer and concomitant relaxation on the monthly grocery budget. Observed anti-bacterial potency of PHS is attributed to the disruption of bacterial cell membrane, as employed by alcohol-based hand sanitizers. A rough estimation revealed that PHS is ~ 4.3 times cost effective than the standard hand sanitizer used as the positive control in this study. Taken together, PHS is a suitable alternative for existing hand sanitizers available in the market that can relax the demand-supply strain and soften significantly the burden of monthly expenditure on hand sanitizers.
新冠疫情几乎使手部消毒成为一种日常习惯,导致手部消毒频率急剧增加,洗手液需求空前激增。事实上,一些政府不得不对零售商店和非处方药店的洗手液实行定量供应。此外,印度政府还对洗手液价格设了上限。目前,全球和印度的大部分人口都在金融危机中挣扎。因此,强制手部消毒在本就难以维持的购物清单上又增添了一项不受欢迎但又不可避免的内容。在此,我们将帕坦伽利阿育吠陀有限公司(一家总部位于印度的食品和草药公司)研发并销售的帕坦伽利洗手液(PHS)的抗菌效果与目前临床环境中使用的最顶级洗手液之一进行了比较。PHS的抗菌效果与标准洗手液相当。此外,纸片扩散法和时间依赖性拇指印迹试验表明,PHS在涂抹表面的滞留时间更长,这表明洗手液的消耗量更少,同时也能缓解每月购物预算的压力。观察到的PHS的抗菌效力归因于其对细菌细胞膜的破坏作用,这与酒精类洗手液的作用方式相同。粗略估计显示,PHS的性价比约为本次研究中用作阳性对照的标准洗手液的4.3倍。综上所述,PHS是市场上现有洗手液的合适替代品,它可以缓解供需紧张局面,并显著减轻每月购买洗手液的支出负担。